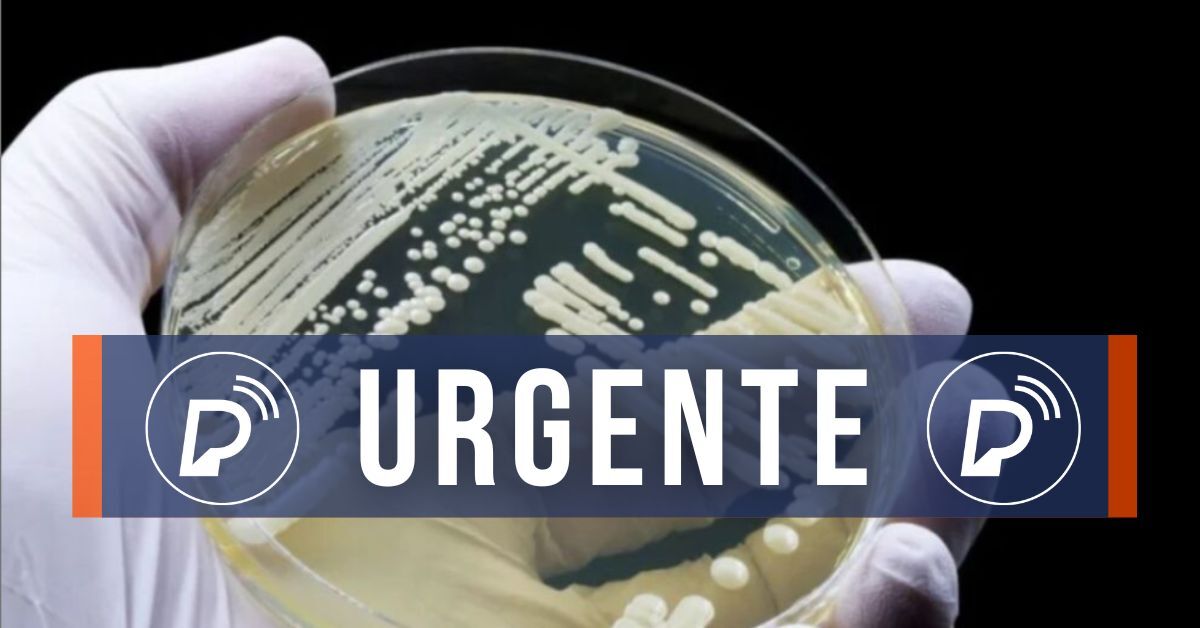

Pernambuco, 17 de Abril de 2026

Ouça a Rádio Portal

Em Pernambuco, primeiro caso de superfungo de 2025 é confirmado pela Secretaria de Saúde Foto: Imagem Ilustrativa / Pixabay
A Secretaria Estadual de Saúde (SES-PE) confirmou o primeiro caso do fungo Candida auris (C. auris) no Hospital Otávio de Freitas (HOF), no Recife. O resultado laboratorial positivo foi detectado por meio de vigilância hospitalar de rotina em uma paciente do sexo feminino, de 51 anos - com relato de obstrução intestinal e histórico de tratamento quimioterápico -, internada na Unidade de Terapia Intensiva do serviço de saúde, desde o último dia 31 de janeiro.
Com o diagnóstico positivo para C.auris, visando o monitoramento dos pacientes acompanhados no setor, a direção da unidade e a Central Estadual de Regulação de Leitos suspenderam a ocorrência de novas admissões na UTI onde a paciente está internada.
Ao todo, contando com a paciente citada, 20 pacientes serão monitorados e seguirão o protocolo de testagem para a doença. A paciente não apresenta sintomas relacionados à presença da Candida, e no momento segue recebendo tratamento da equipe multidisciplinar para restabelecimento da condição clínica.
A Agência Pernambucana de Vigilância Sanitária (Apevisa), junto a Comissão de Controle de Infecção Hospitalar (CCIH) do Otávio de Freitas, já iniciou as ações voltadas para prevenção e controle de possíveis novas colonizações por Candida no serviço de saúde.
Entre outras medidas de controle de infecção para prevenção da transmissão de C. auris que devem ser executadas em ambientes de saúde, tem-se higiene das mãos, uso apropriado de equipamento de proteção e outras precauções e a limpeza e desinfecção do ambiente de atendimento do paciente e de equipamentos reutilizáveis com produtos recomendados.
Ainda sob condução da Apevisa, visitas no setor de internação deverão ser evitadas, porém em casos de extrema necessidade – a partir da avaliação da equipe assistencial -, os familiares dos pacientes deverão ser orientados quanto à importância do uso de Equipamentos de Proteção Individual (EPI’s).
Da redação do Portal de Prefeitura com informações da Secretaria Estadual de Saúde (SES-PE)
1
2
3
04:49, 17 Abr

25
°c
Fonte: OpenWeather
Os ingressos começam a ser vendidos neste mês. A nova fase do espetáculo reúne diferentes momentos da trajetória do grupo.
De acordo com o MPPE, um terreno público teria sido concedido de forma irregular a uma empresa ligada a empresário aliado do ex-gestor municipal, que nega irregularidades.
O instituto ouviu 1.022 eleitores de 13 a 15 de abril. O estudo foi registrado no TSE com o número PE-04713/2026.
mais notícias
+